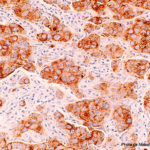

Découverte d’une nouvelle cible thérapeutique associée aux mutations BRCA1/2 dans les cancers
26/09/2025
Publiés dans Nature Communications, les travaux de l’équipe de la Dr Sophie Postel-Vinay à Gustave Roussy mettent en évidence une nouvelle cible thérapeutique : l’enzyme ADAR1, susceptible d’être exploitée dans le traitement de certains cancers du sein, de l’ovaire, de la prostate et du pancréas.
L’équipe de la Dr Sophie Postel-Vinay à Gustave Roussy a identifié une nouvelle cible thérapeutique, l’enzyme ADAR1, qui pourrait être utilisée pour traiter certains cancers liés aux mutations des gènes BRCA1 et BRCA2. Ces mutations rendent les tumeurs agressives en perturbant la réparation de l’ADN, mais l’inhibition d’ADAR1 peut entraîner une accumulation de dommages dans les cellules tumorales, menant à leur destruction. Cette approche repose sur le concept de létalité synthétique, où la combinaison de deux altérations spécifiques entraîne la mort des cellules cancéreuses.
Les chercheurs espèrent développer des inhibiteurs d’ADAR1 pour des essais cliniques chez les patients dont les cancers ne répondent pas aux traitements conventionnels.